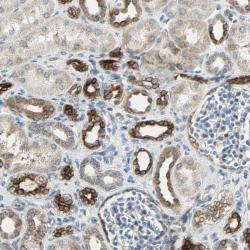

Antibody data
- Antibody Data
- Antigen structure
- References [1]
- Comments [0]
- Validations
- Immunohistochemistry [1]
Submit
Validation data
Reference
Comment
Report error
- Product number
- sc-28331 - Provider product page

- Provider
- Santa Cruz Biotechnology
- Proper citation
- Santa Cruz Biotechnology Cat#sc-28331, RRID:AB_672377
- Product name
- Anti-PKD2
- Antibody type
- Monoclonal
- Antigen
- Recombinant full-length protein
- Reactivity
- Human
- Host
- Mouse
Submitted references Polycystin-2 activation by inositol 1,4,5-trisphosphate-induced Ca2+ release requires its direct association with the inositol 1,4,5-trisphosphate receptor in a signaling microdomain.
Sammels E, Devogelaere B, Mekahli D, Bultynck G, Missiaen L, Parys JB, Cai Y, Somlo S, De Smedt H
The Journal of biological chemistry 2010 Jun 11;285(24):18794-805
The Journal of biological chemistry 2010 Jun 11;285(24):18794-805
No comments: Submit comment
Supportive validation
- Submitted by
- per
- Main image
- Experimental details
- Immunohistochemical staining of human kidney shows strong cytoplasmic positivity in cells in tubule.
- Validation comment
- Staining pattern partly consistent with experimental and/or bioinformatic data.